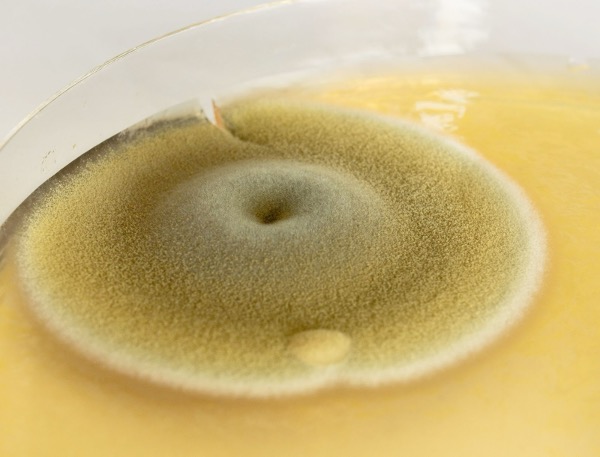

Stanley Picker Gallery at Kingston University with Warwick Institute of Engagement at University of Warwick are happy to be joining as new partners Artangel, Science Gallery London at King’s College London, and Radar at Loughborough University on Making Time, a development programme that supports artists to embed environmental consciousness in their practice.
The second iteration of the Making Time is an 18 month year-long research programme that will support artists Claire Baily, Taey Iohe, Nastassja Simensky and Undead Matter to explore and experiment with repositioning the planet as a primary stakeholder in the development of their ideas.
The programme highlights the importance of interdisciplinary knowledge and collaboration, bringing together artists, scientists and researchers. New nationwide partners are joining us to support artists as they think through and alter their practices in light of our growing understanding about the environment.
Making Time was first launched in 2023 including several of our recent and current Stanley Picker Fellows Dani Admiss, FRAUD, Abbas Zahedi and Rachel Pimm.
Hear the artists discuss their experience and their research in a conversation with Mariam Zulfiqar, Director of Artangel, available to listen to HERE.
Biography
Claire Baily is a London-based artist, researcher, and educator whose work navigates the intersections of art, sustainability, and material innovation. Looking to develop regenerative making systems built around plant-based materials she will be focusing on the historical and contemporary uses of biopolymers such as starch and natural fibres such as flax, nettle and hemp. Emphasising slowness, attentiveness and embodied engagement, Claire draws on the embedded histories of materials and their production to reimagine how stories are told and shared. She approaches each material as a site of layered narratives, where making becomes a way to participate in interconnected lifecycles.
Taey Iohe is an artist, writer, and listener, born near the Han River and now based by the River Lea and Ching. Working fluidly across sound, language, moving image, and collective practice, their work is rooted in the anti-colonial sense of belonging, tracing forms of leakage across bodies, landscapes, and archives through an eco-crip and queer feminist lens. Attuned to environmental hormones, reproductive justice, and racial biopolitics, Taey is drawn to what leaks—from bodily thresholds to planetary systems—as both a sign of harm and a gesture toward repair. Their practice examines what travels and transforms across borders in waterways and ecotone zones, with a current focus on the Thames Estuary and Derry.
Nastassja Simensky is an artist with an interest in critical heritage and the unevenly distributed impacts of global energy regimes and extractive processes. Nastassja often works collaboratively with artists and non-artists to make authored and co-authored artworks. During Making Time, Nastassja will develop ‘Dust, Static and Feedback Loops’, a new body of research seeded through a residency with Artica in Svalbard in 2024. Research will consider how the transmission of aeolian dust, environmental toxicity and static/noise might operate both as objects of scientific scrutiny and as poetic devices through which to explore the material and political composition of atmospheric infrastructures and their unevenly distributed effects.
Undead Matter is a multidisciplinary, collaborative practice initiated and convened by Sophie J Williamson, an artist, curator, writer based in London and Margate, that focuses on the blurred edges of life and non-life, focused on the intimacy of dying, and its dialogue with geology, ecology and planetary futures. From a newly disabled body (imprinted by the shifting ecologies of the Anthropocene, after Williamson was bitten by a tick in 2023), Undead Matter is currently navigating unexpected outcomes from forced rest, unproductivity and learning about survival through crip allyship across species.